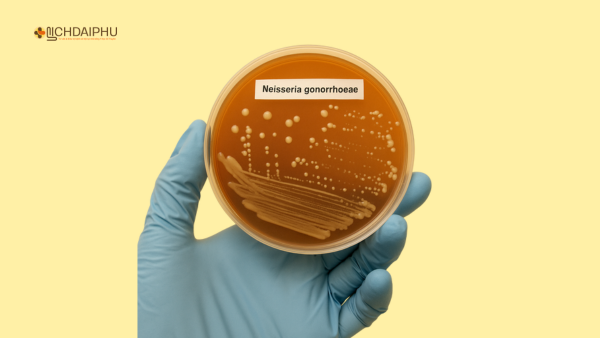
Nuôi cấy vi khuẩn lậu Neisseria gonorrhoeae trong phòng xét nghiệm

Bệnh lậu không có triệu chứng là một trong những dạng nguy hiểm và dễ bị bỏ qua nhất của bệnh lậu. Người mắc không cảm thấy đau, không có dấu hiệu rõ rệt, nhưng vi khuẩn vẫn âm thầm phát triển và có thể lây lan sang người khác hoặc gây biến chứng nghiêm trọng nếu không được phát hiện và điều trị kịp thời.
- Bệnh lậu không biến chứng là gì? Cách điều trị ra sao?
- Bệnh lậu uống thuốc bao lâu thì khỏi? Cấp tính, mãn tính, tái phát
- Quan hệ bằng miệng có bị lây bệnh lậu không?

Trong bài viết này, chúng ta sẽ cùng tìm hiểu bệnh lậu không triệu chứng là gì, vì sao nó xảy ra, cách nhận biết chính xác, và hướng điều trị hiệu quả nhất hiện nay.
Bệnh lậu không có triệu chứng là gì?
Bệnh lậu là một bệnh lây truyền qua đường tình dục (STD) do vi khuẩn Neisseria gonorrhoeae gây ra. Vi khuẩn này chủ yếu tấn công vào niêm mạc của bộ phận sinh dục, hậu môn, miệng và mắt.
Thông thường, bệnh lậu biểu hiện bằng các triệu chứng như tiểu buốt, chảy mủ ở dương vật, khí hư bất thường ở nữ giới… Tuy nhiên, có tới 50 – 80% phụ nữ và khoảng 10 – 15% nam giới không có triệu chứng rõ ràng trong suốt thời gian nhiễm bệnh. Đây được gọi là bệnh lậu không triệu chứng (asymptomatic gonorrhea).

Nguyên nhân gây ra tình trạng không triệu chứng
-
Hệ miễn dịch mạnh khiến cơ thể hạn chế phản ứng viêm – không gây biểu hiện lâm sàng rõ ràng.
-
Nhiễm trùng nhẹ, khu trú tại một vị trí nhỏ như cổ tử cung, niệu đạo hoặc hầu họng.
-
Giới tính và cơ địa: Phụ nữ có tỷ lệ mắc lậu không triệu chứng cao hơn nam giới.
-
Tái nhiễm nhiều lần, dẫn đến hiện tượng “chai lì” phản ứng của cơ thể với vi khuẩn.

Những ai có nguy cơ mắc bệnh lậu không triệu chứng?
-
Quan hệ tình dục không an toàn (không dùng bao cao su).
-
Có nhiều bạn tình hoặc bạn tình không rõ tình trạng sức khỏe.
-
Quan hệ bằng miệng, hậu môn mà không có biện pháp bảo vệ.
-
Tiếp xúc với dịch mủ, máu, chất nhầy chứa vi khuẩn.
-
Đã từng mắc bệnh lậu hoặc các bệnh xã hội khác trước đó.
📌 Lưu ý: Dù không có triệu chứng, người mắc vẫn có khả năng lây bệnh sang người khác và có thể dẫn đến các biến chứng nghiêm trọng như vô sinh, viêm vùng chậu, chửa ngoài tử cung…
Cách nhận biết chính xác bệnh lậu không có triệu chứng
Mặc dù không có dấu hiệu rõ ràng, vẫn có một số biểu hiện kín đáo hoặc dấu hiệu gián tiếp có thể giúp nhận biết:
1. Có tiếp xúc nguy cơ cao
-
Quan hệ tình dục với người chưa rõ tình trạng sức khỏe.
-
Có tiền sử mắc hoặc tiếp xúc gần với người nhiễm bệnh lậu.
-
Quan hệ bằng miệng hoặc hậu môn mà không dùng bao cao su.
Nếu có yếu tố nguy cơ trên, bạn cần xét nghiệm kiểm tra định kỳ dù không thấy biểu hiện lạ.
2. Xuất hiện triệu chứng nhẹ và mơ hồ
Ở nữ giới:
-
Khí hư tăng nhẹ, có thể vàng nhạt hoặc trắng đục.
-
Cảm giác lâm râm vùng bụng dưới hoặc đau nhẹ khi quan hệ.
-
Chảy máu âm đạo bất thường giữa kỳ kinh, dễ nhầm với rối loạn nội tiết.
Ở nam giới:
-
Cảm giác ngứa nhẹ hoặc châm chích ở niệu đạo.
-
Đôi lúc tiểu hơi rát, nhưng không rõ ràng.
-
Dịch tiết đầu dương vật vào sáng sớm nhưng số lượng ít.

3. Dấu hiệu toàn thân gián tiếp
-
Mệt mỏi kéo dài không rõ nguyên nhân.
-
Sốt nhẹ, hạch bẹn sưng (hiếm gặp).
-
Đau tinh hoàn nhẹ hoặc vùng chậu khó chịu mơ hồ.
✅ Trong nhiều trường hợp, chỉ xét nghiệm tầm soát định kỳ mới phát hiện được bệnh lậu không triệu chứng.
Các phương pháp xét nghiệm chẩn đoán chính xác
1. Xét nghiệm khuẩn lậu bằng PCR (NAATs)
-
Độ chính xác cao, phát hiện cả trường hợp không triệu chứng.
-
Lấy mẫu dịch niệu đạo, cổ tử cung, trực tràng hoặc họng tùy vị trí nghi ngờ.
2. Xét nghiệm soi tươi dịch tiết (nam giới có thể có mủ nhẹ)
-
Dành cho nam giới có một chút dịch vào sáng sớm.
3. Nuôi cấy vi khuẩn
-
Xác định chính xác chủng vi khuẩn, đồng thời kiểm tra bệnh lậu kháng thuốc.
Bệnh lậu không triệu chứng có nguy hiểm không?
CÓ. Dù không biểu hiện, nhưng vi khuẩn vẫn sinh sôi và phá hủy âm thầm bên trong cơ thể:
Ở nữ giới:
-
Gây viêm cổ tử cung, viêm vòi trứng, viêm vùng chậu.
-
Gây chửa ngoài tử cung, vô sinh nếu vòi trứng bị tắc.
-
Nguy cơ truyền sang con khi sinh thường → gây viêm kết mạc mắt ở trẻ sơ sinh.
Ở nam giới:
-
Gây viêm mào tinh hoàn, viêm tuyến tiền liệt, tắc ống dẫn tinh.
-
Dễ lây nhiễm HIV nếu không điều trị kịp thời.
Cách điều trị bệnh lậu không triệu chứng hiệu quả
Dù không có biểu hiện, người bệnh vẫn cần điều trị theo đúng phác đồ để tránh biến chứng và lây lan.
1. Phác đồ Tây y tiêu chuẩn
-
Tiêm Ceftriaxone 250 – 500mg (một liều duy nhất).
-
Uống Azithromycin 1g kết hợp nếu nghi ngờ nhiễm chlamydia.
👉 Áp dụng cho cả người bệnh và bạn tình (dù không có triệu chứng) để tránh tái nhiễm.
Lưu ý: Sử dụng kháng sinh người bệnh cần có chỉ định của bác sĩ, không được tự ý sử dụng để tránh những hậu quả không mong muốn.
2. Điều trị bằng thuốc Đông y dạng viên hoàn
Một số người chọn phương pháp điều trị Đông y để ngăn tái phát, tăng đề kháng:
-
Dùng thuốc viên hoàn Đông y Lịch Đại Phu theo liệu trình 6 – 9 ngày.
-
Thành phần từ xuyên tâm liên, kim ngân hoa, bồ công anh…
-
Tác dụng: Kháng khuẩn, tiêu viêm, thanh nhiệt, giải độc.


📌 Xem chi tiết liệu trình điều trị tại nhà:
👉 Thuốc đông y viên hoàn điều trị bệnh lậu tại nhà hiệu quả từ Lịch Đại Phu
Lời khuyên dành cho người nghi ngờ nhiễm lậu không triệu chứng
-
Chủ động đi xét nghiệm nếu có tiếp xúc nguy cơ, dù không có biểu hiện.
-
Không nên tự ý mua thuốc điều trị tại nhà.
-
Điều trị song song với bạn tình.
-
Tránh quan hệ tình dục cho đến khi khỏi hoàn toàn.
-
Tái khám sau 7 – 10 ngày hoặc theo lịch của bác sĩ.
-
Sử dụng bao cao su đúng cách trong mọi hình thức quan hệ.

Kết luận
Bệnh lậu không có triệu chứng là mối nguy hiểm thầm lặng. Việc không phát hiện kịp thời có thể khiến người bệnh không chỉ gây lây lan mà còn đối mặt với những biến chứng nguy hiểm về sinh sản và sức khỏe tổng thể.
Nếu bạn nghi ngờ bản thân đang nhiễm hoặc từng có hành vi nguy cơ cao, hãy đi xét nghiệm sớm. Điều trị kịp thời sẽ giúp chữa khỏi bệnh, tránh ảnh hưởng lâu dài và bảo vệ bạn tình.
Lịch Đại Phu
